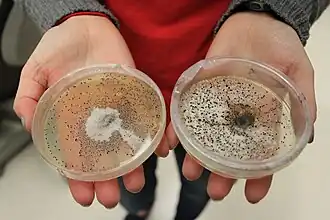
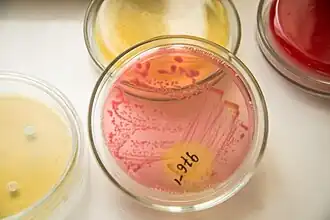

Microbiologische cultuur
Een microbiologische cultuur of microbiële cultuur is een techniek waarbij micro-organismen, zoals bacteriën of schimmels, onder gecontroleerde omstandigheden worden gekweekt. De organismen kunnen op een geschikte voedingsbodem of in een kweekmedium uitgroeien tot een genetisch identieke kolonie. Het kweken, isoleren en karakteriseren van micro-organismen staat aan de basis van vele methoden in de moleculaire biologie, microbiologie en klinische diagnostiek.
Onderzoekers maken microbiële culturen voor verschillende doeleinden. De micro-organismen in een cultuur kunnen bijvoorbeeld ingezet worden voor biotechnologische productieprocessen, zoals de aanmaak van enzymen, vitaminen of antibiotica. Bacteriën zoals E. coli zijn op een agarplaat makkelijk te vermenigvuldigen, te zuiveren en genetisch te manipuleren.
Bacterieculturen
Bacteriën kunnen gekweekt worden in petrischalen die voorzien zijn van een dunne laag groeimedium op basis van agar.[1] Zodra het groeimedium in de petrischaal geënt of uitgeplaat is met de gewenste bacteriestam, worden de platen geïncubeerd bij de optimale temperatuur voor de groei van de geselecteerde bacteriën (gewoonlijk bij 37° C, de menselijke lichaamstemperatuur, of lager voor milieuculturen). Na ongeveer een dag ontstaan er zichtbare kolonies op de agarplaat. Zodra het gewenste groeiniveau is bereikt, kunnen de agarplaten gedurende langere tijd ondersteboven in een koelkast worden bewaard.
Aan het groeimedium kunnen verschillende additieven worden toegevoegd. Sommige bacteriën kunnen alleen groeien in aanwezigheid van bepaalde nutriënten, zoals aminozuren of zouten. Dit principe wordt vaak gebruikt bij het maken van genetische gemanipuleerde bacteriestammen die een antibioticum-resistentiegen bevatten. Wanneer het geselecteerde antibioticum aan de agar wordt toegevoegd, kunnen alleen bacteriecellen die het resistentiegen bevatten, groeien. Op deze manier kan een onderzoeker gericht de kolonies selecteren, bijvoorbeeld degenen die met succes zijn getransformeerd.[2][3]
Bacteriën kunnen ook worden opgegroeid in vloeibaar medium, een zogenaamde suspensiecultuur. Veelal gebeurt dit in een rechtopstaande erlenmeyer. Het gebruik van vloeibaar medium laat toe dat de onderzoeker grote hoeveelheden bacteriën kan kweken voor verschillende toepassingen, zoals het vermenigvuldigen (kloneren) van plasmide-DNA met daarop een gen van interesse. Een bekend vloeibaar medium is LB-medium.
Zie ook
Bronnen
- (en) Alberts, B. (2015). Molecular Biology of The Cell, 6th edition. Garland Science, New York, p. 440. ISBN 978-0-8153-4464-3.
- ↑ (en) Hine, R. (2019). A Dictionary of Biology, 8th. Oxford University Press. ISBN 978-0-19-882148-9.
- ↑ (en) Madigan, Michael T. (2019). Brock Biology of Microorganisms, 15th. Pearson. ISBN 978-1-292-23510-3.
- ↑ (en) Uruburu, F. (2003). History and services of culture collections. International Microbiology 6 (2): 101–103. PMID 12811589. DOI: 10.1007/s10123-003-0115-2.